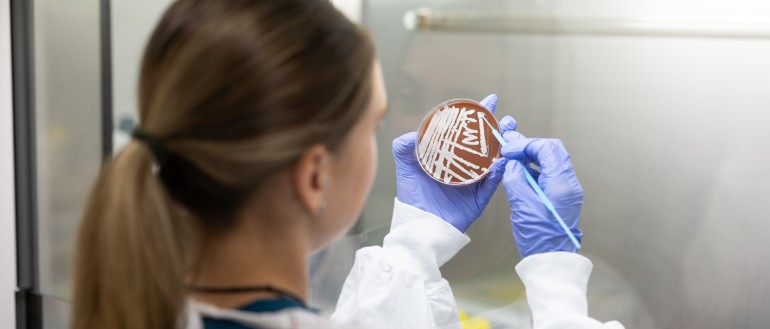
Melioidosis

Melioidosis is a potentially life-threatening disease caused by the soil-dwelling bacterium, Burkholderia pseudomallei.
Melioidosis is a common cause of serious pneumonia and blood poisoning in the Northern Territory (NT), Australia. The bacteria live below the soil's surface during the dry season, but after heavy rainfall can move to surface water and mud. They can then become airborne.
Recent wet seasons have seen a dramatic increase in cases of melioidosis. As Darwin’s urban areas spread and irrigation schemes and agriculture encroach into the desert, there is an even greater risk of spread of melioidosis.
Our research focus:
- To reduce the number of deaths from melioidosis, through early diagnosis.
Our research impact:
- Helped to halve the death rate of melioidosis in the NT through a 31+-year prospective study—The Darwin Prospective Melioidosis Study (DPMS). With faster diagnosis and treatment, mortality rates fell from over 30% to around 10%.
- Documented and described the very diverse range of melioidosis symptoms through the analysis of over 1000 cases
- Defined the incubation period for melioidosis and the frequency of chronic disease and reactivation
- Developed the current treatment guidelines for melioidosis, which are now used globally
- Genetic profiling of Australian B. pseudomallei bacteria suggests that the bacterium evolved in Australia and then spread to Southeast Asia and further afield
- Discovered that introduced grasses in the NT harbour particularly high numbers of melioidosis bacteria. This discovery may well impact current agricultural development in Northern Australia where non-native grasses are widely planted
- Found that melioidosis bacteria may be carried and spread by birds
- Discovered that melioidosis bacteria are common in un-chlorinated bore water in the NT
- Described using genomics the first confirmed linkage of B. pseudomallei in storm air samples to an individual case of inhalational melioidosis
- Tested a number of new “point of care” diagnostics that are now being used in resource-poor settings overseas
- Used genomics to identify melioidosis transmission routes from environment to both humans and animals
- With veterinary colleagues described epidemiological and clinical aspects of melioidosis in animals, including in novel species
- Taken on responsibility for curating the MLST database of global B. pseudomallei from colleagues around the world.
Key staff:
- Prof Bart Currie
- Mark Mayo
- Dr Mirjam Kaestli
- Linda Ward
- Kelly McCrory
- Celeste Woerle
- Vanessa Rigas
- Darwin Prospective Melioidosis Study (D.P.M.S)
- The melioidosis agent Burkholderia pseudomallei in the anthropogenic environment of northern
Australia - Closing the loop on melioidosis
- Linking genomics of Burkholderia pseudomallei to melioidosis: diversity of clinical manifestations, changing epidemiology and microevolution in chronic carriage
- Characterisation of Burkholderia pseudomallei using unique genomic components.
- Melioidosis in Malaysian Borneo
- Burkholderia pseudomallei in Australia: A perspective of distribution and source attribution
- The occurrence of the melioidosis agent, Burkholderia pseudomallei, in scats from captive and wild animals in the Darwin region.
- Majoni, S.W., Hughes, J.T., Heron, B., Currie, B.J. (2017) Trimethoprim+sulfamethoxazole reduces rates of melioidosis in high risk haemodialysis patients. Kidney International Reports. (accepted 12 Sept 2017). www.kireports.org/#/article/S2468-0249(17)30391-1/fulltext
- Wiersinga, W. J., Currie, B. J., & Peacock, S. J. (2012). Medical progress: Melioidosis. New England Journal of Medicine, 367(11), 1035-1044.
- Sarovich, D. S., Price, E. P., von Schulze, A. T., Cook, J. M., Mayo, M., Watson, L. M., et al. (2012). Characterization of ceftazidime resistance mechanisms in clinical isolates of burkholderia pseudomallei from Australia. PLoS ONE, 7(2).
- Parameswaran, U., Baird, R. W., Ward, L. M., & Currie, B. J. (2012). Melioidosis at royal darwin hospital in the big 2009-2010 wet season: Comparison with the preceding 20 years. Medical Journal of Australia, 196(5), 345-348.
- Meumann, E. M., Cheng, A. C., Ward, L., & Currie, B. J. (2012). Clinical features and epidemiology of melioidosis pneumonia: Results from a 21-year study and review of the literature. Clinical Infectious Diseases, 54(3), 362-369.
- Kaestli, M., Schmid, M., Mayo, M., Rothballer, M., Harrington, G., Richardson, L., et al. (2012). Out of the ground: Aerial and exotic habitats of the melioidosis bacterium Burkholderia pseudomallei in grasses in Australia. Environmental Microbiology, 14(8), 2058-2070.
- Kaestli, M., Richardson, L. J., Colman, R. E., Tuanyok, A., Price, E. P., Bowers, J. R., et al. (2012). Comparison of TaqMan PCR assays for detection of the melioidosis agent Burkholderia pseudomallei in clinical specimens. Journal of Clinical Microbiology, 50(6), 2059-2062.
- Mayo, M., Kaestli, M., Harrington, G., Cheng, A. C., Ward, L., Karp, D., et al. (2011). Burkholderia pseudomallei in unchlorinated domestic bore water, tropical northern Australia. Emerging Infectious Diseases, 17(7), 1283-1285.
- Mattar, S., Hampton, V., Kaestli, M., Mayo, M., Choy, J. L., Harrington, G., et al. (2011). Melioidosis in birds and burkholderia pseudomallei dispersal, Australia. Emerging Infectious Diseases, 17(7), 1310-1312.
- Currie, B. J., Ward, L., & Cheng, A. C. (2010). The epidemiology and clinical spectrum of melioidosis: 540 cases from the 20 year darwin prospective study. PLoS Neglected Tropical Diseases, 4(11).
- Currie, B. J., Haslem, A., Pearson, T., Hornstra, H., Leadem, B., Mayo, M., et al. (2009). Identification of melioidosis outbreak by multilocus variable number tandem repeat analysis. Emerging Infectious Diseases, 15(2), 169-174.

.JPG&w=123&h=126)